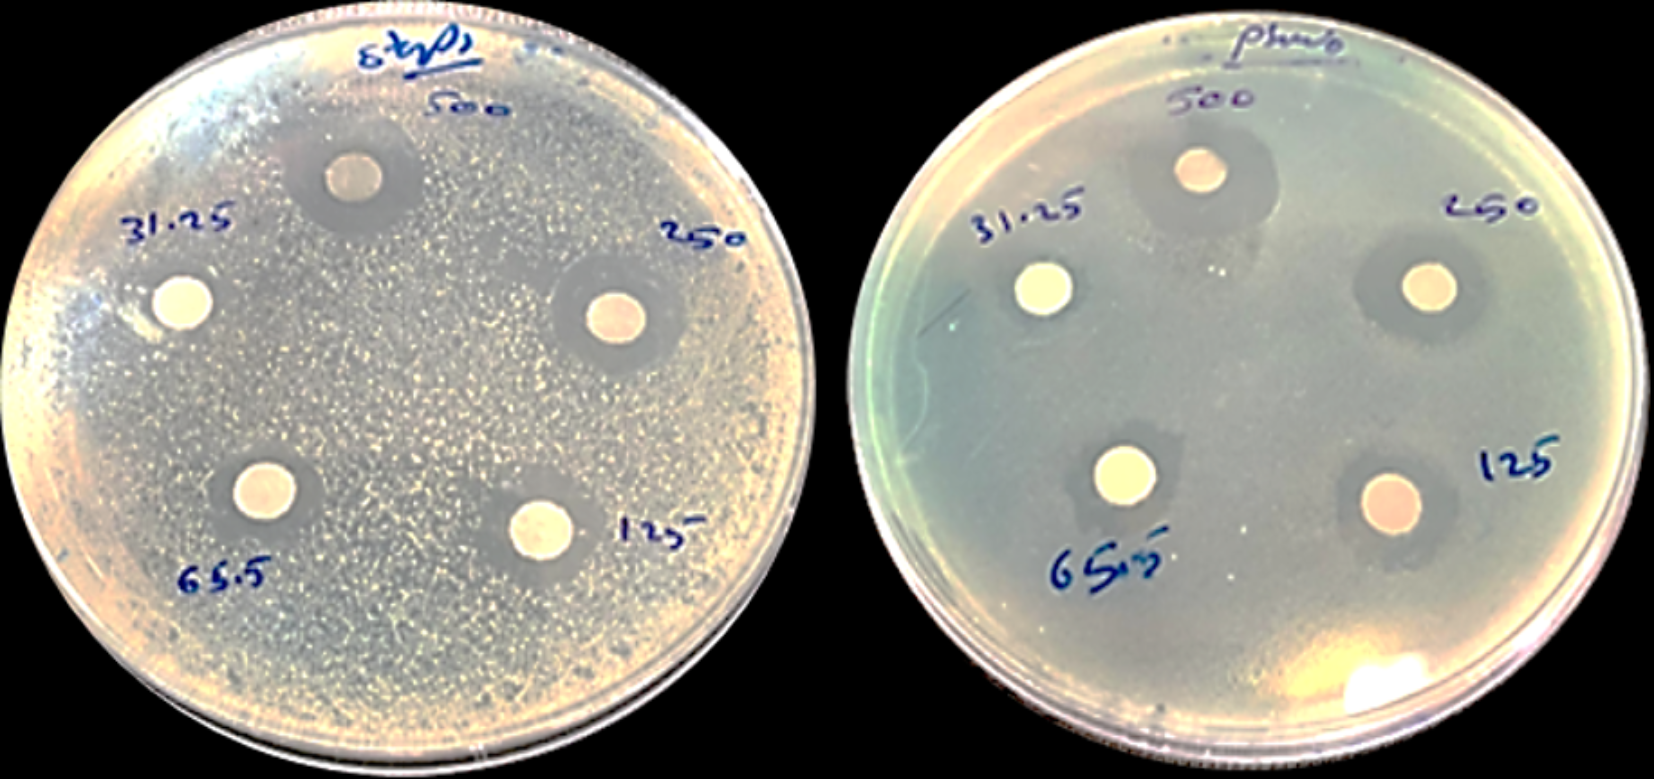
Fig. 8

Fig. 8

The sensitivity test of AgNPs showed different concentrations of Gram-positive, Streptococcus pneumoniae (A), Gram-negative, and Pseudomonas aeroginosa. (B) Cultured on Muller-Hinton agar.
The sensitivity test of AgNPs showed different concentrations of Gram-positive, Streptococcus pneumoniae (A), Gram-negative, and Pseudomonas aeroginosa. (B) Cultured on Muller-Hinton agar.